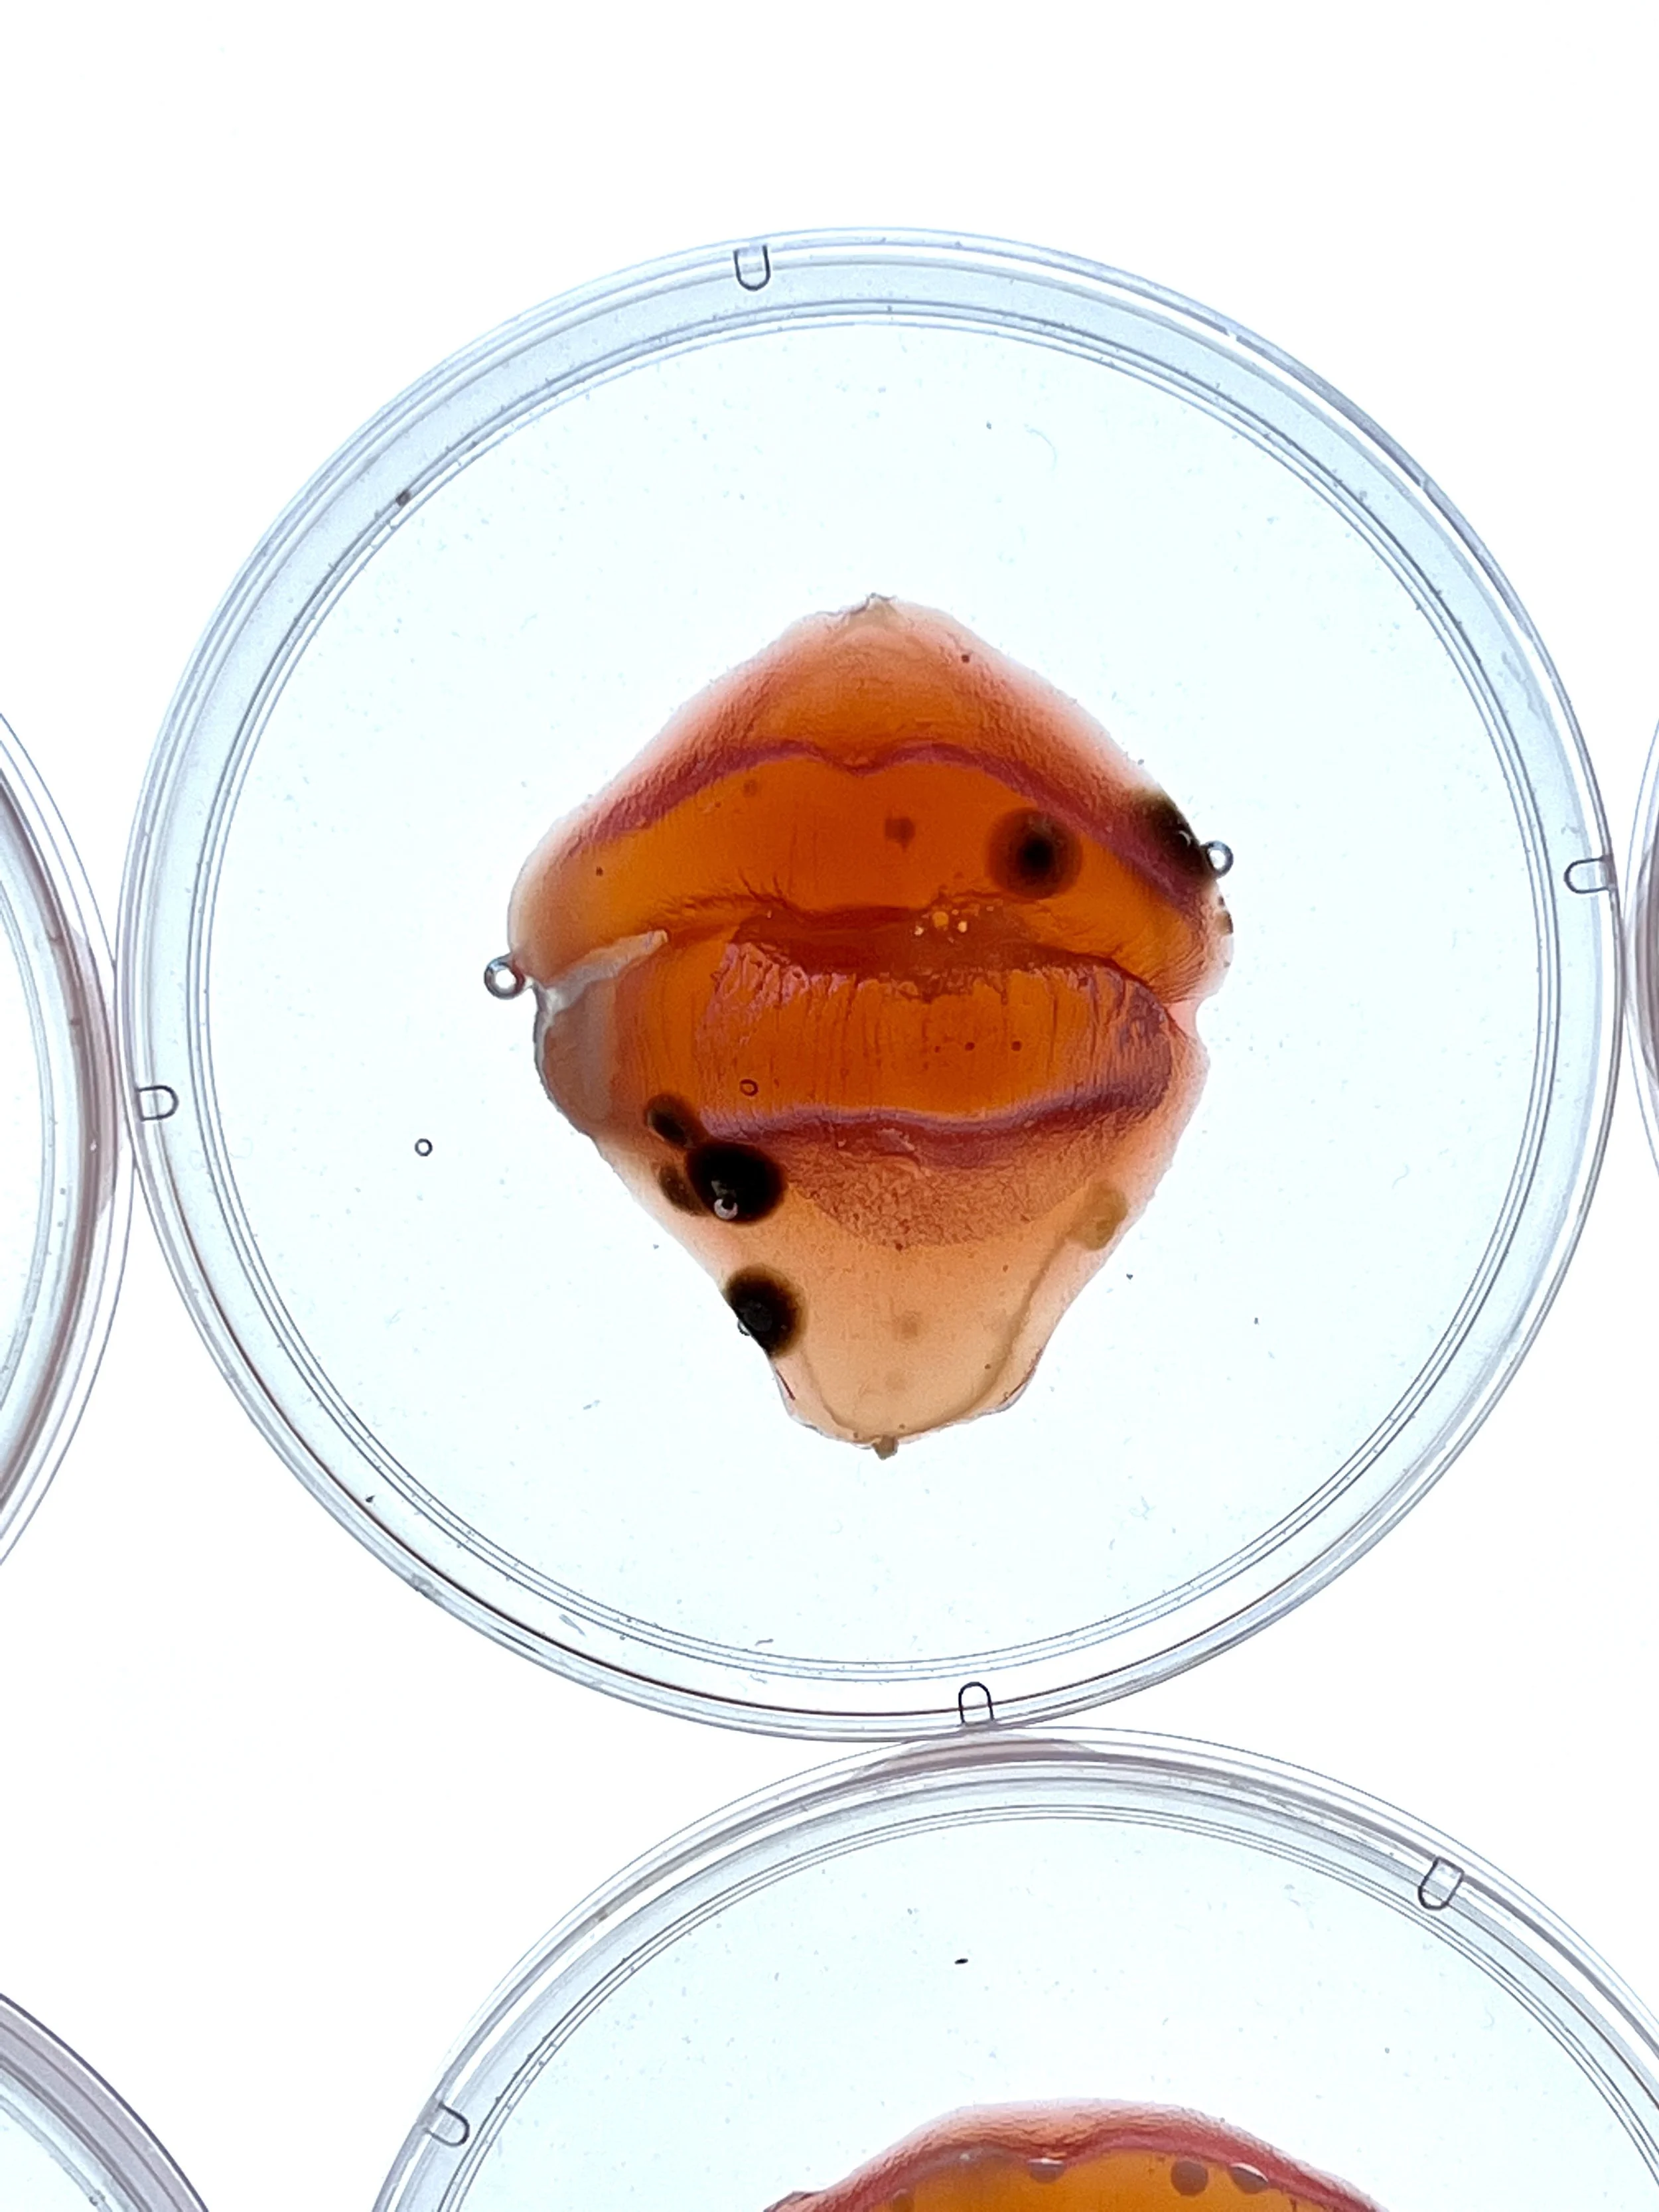

Microbial Self Portraits
A series of self portraits exploring a decentralized identity composed of the multi-species constellation that is a microbiome. This project examines the impact of microorganisms living in the body that impact mood and behavior- elements that we typically associate with a sense of “self”, but is co-made with other species.
How much of our identity is predestined by our DNA, and how much of our behavior is influenced by the constellation of microorganisms that reside in, on, and around us? What is genetic exchange without intimacy? What invisible forces co-make me?
The bacteria that live on your body outnumber your own cells. While we have 23,000 genes, our microbiome can contain up to 2 million unique bacterial genes. There is a lot of emerging research on the role of all the microorganisms cohabit our body and personal traits, such as mood, behavior and health. These findings unseat our relationship with notions of identity and genetic determinism; do I exhibit certain traits because of genes I inherited from my mother, because of the environment I was raised in, or because of the biome I have acquired through a lifetime of kissing and touching?
Reflecting on these emerging findings, I have created a speculative love note of the future- design objects through which we might exchange these precious signatures of bacteria with each other. If genetic fitness used to be a traditional parameter by which you might choose a spouse, what of their microbial wealth?
medium
petri dish, custom molded LB Agar, micro-organisms cultured from a kiss
dimensions
4" x 4" x .7"
year
2015-2022
exhibitions
Paul Robeson Gallery at Rutgers
Boston Center for the Arts
tags
Identity, inter-species, multiplicity, microbiome, ecology
related readings: